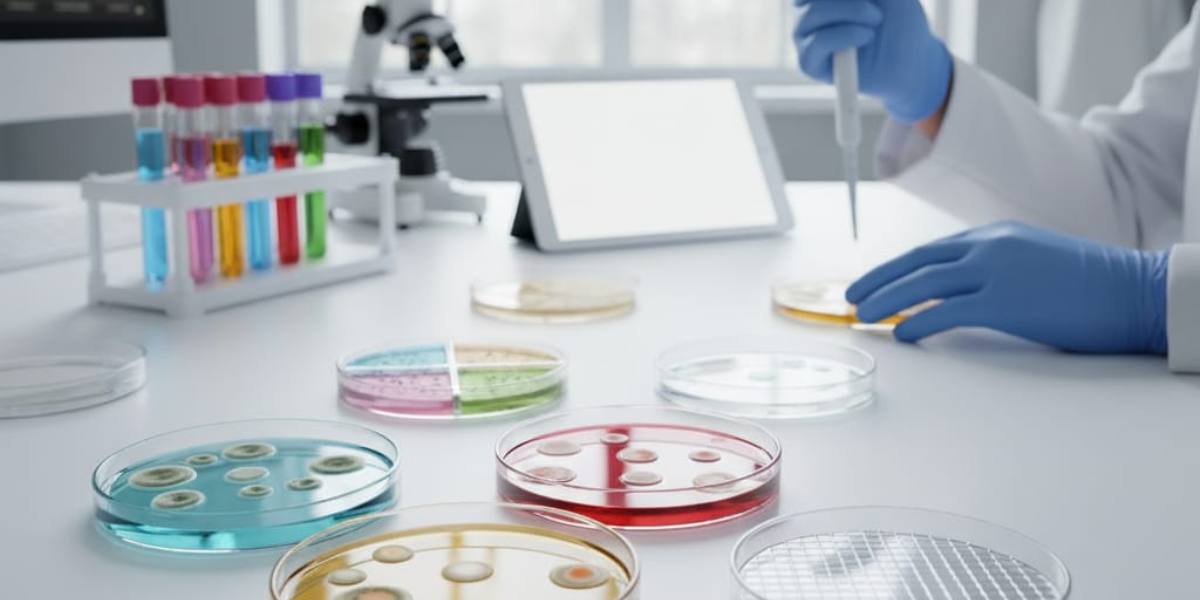
Suministros Vilchis | La Trazabilidad en Insumos de Laboratorio: Garantía de Calidad y Confianza

En el riguroso mundo de la investigación científica y el diagnóstico clínico, la precisión es la base sobre la que se construyen resultados confiables. Cada elemento dentro de un laboratorio, desde el equipo más avanzado hasta el insumo más básico, influye directamente en la calidad del resultado final. Por ello, la trazabilidad en los insumos de laboratorio se convierte en un componente esencial del control de calidad, garantizando que cada etapa —desde la fabricación hasta la entrega— forme parte de una cadena de confianza documentada y segura.
En Suministros Vilchis, entendemos que la trazabilidad no es solo un protocolo, sino un compromiso con la excelencia y la seguridad de nuestros clientes. Detrás de cada muestra existe una decisión crítica, y en disciplinas como la microbiología, conocer la procedencia y manejo de los insumos es innegociable.
¿Qué es la Trazabilidad en los Insumos de Laboratorio?
La trazabilidad de los insumos de laboratorio es la capacidad de rastrear y documentar todo el ciclo de vida de un producto: desde su fabricación, distribución, transporte y uso final, hasta su almacenamiento. Esto implica contar con un registro detallado de su origen, lote, fechas de producción, controles de calidad y condiciones de conservación.
Gracias a esta trazabilidad, se puede responder con precisión a preguntas clave como:
- ¿Quién lo fabricó y cuándo?
- ¿Qué materias primas se utilizaron?
- ¿Qué controles de calidad se aplicaron?
- ¿Cómo se almacenó y transportó?
Cada insumo, ya sea un medio de cultivo, caja Petri, tubo o reactivo, cuenta con un historial documentado que garantiza su integridad y conformidad normativa.
Importancia de la Trazabilidad en el Laboratorio
La trazabilidad en los materiales de laboratorio impacta directamente en la calidad del trabajo científico y el cumplimiento de normas nacionales e internacionales. Sus beneficios incluyen:
1. Garantía de Calidad y Consistencia
Asegura que cada producto cumple con los estándares de calidad requeridos en cada etapa. Esto es esencial para la reproducibilidad de los resultados y la confianza en los análisis.
2. Reproducibilidad Científica
Permite repetir experimentos con materiales equivalentes en composición y calidad, manteniendo la validez de los resultados analíticos.
3. Control y Retiro Eficiente de Productos
En caso de detectar un lote defectuoso, el sistema de trazabilidad facilita su identificación y retiro inmediato, protegiendo la integridad de los procesos y evitando riesgos.
4. Cumplimiento Normativo
Cumple con normas como la NOM-007-SSA3-2011 para laboratorios clínicos, las ISO aplicables y las Buenas Prácticas de Laboratorio (BPL). Esto asegura una operación alineada con los más altos estándares nacionales e internacionales.
5. Optimización del Inventario
Facilita una gestión eficiente de los insumos, evitando caducidades y asegurando la disponibilidad de materiales críticos.
Trazabilidad en Microbiología: Integridad sin Compromisos
En microbiología, la trazabilidad en medios de cultivo y reactivos es determinante. Una mínima contaminación o degradación puede invalidar una investigación completa. Por eso, cada entrega de Suministros Vilchis cuenta con historial de control y procedencia documentada, garantizando integridad en cada análisis.
Aplicaciones clave:
- Aislamiento e identificación de microorganismos: asegurando crecimiento y caracterización correctos.
- Pruebas de sensibilidad antimicrobiana: manteniendo pH y composición exactos.
- Control de calidad en alimentos y fármacos: evitando interferencias en la detección de patógenos.
Trazabilidad en la Cadena de Distribución
En Suministros Vilchis, la trazabilidad continúa durante todo el proceso de distribución de materiales de laboratorio. Cada pedido está respaldado por un control logístico auditable, que garantiza condiciones óptimas de temperatura, higiene y empaque.
Nuestro sistema de trazabilidad garantiza:
- Certeza en la procedencia: documentamos el origen y la cadena de custodia de cada producto.
- Manejo y almacenamiento óptimos: cumplimos las especificaciones del fabricante para preservar la calidad.
- Documentación completa: incluimos certificados de análisis y datos de lote en cada entrega.
Conclusión: Un Compromiso con la Confianza Científica
La trazabilidad en los insumos de laboratorio es mucho más que un requisito técnico: es una garantía de confianza científica. Permite a los laboratorios respaldar sus resultados, a los investigadores reproducir hallazgos y a los profesionales de la salud ofrecer diagnósticos confiables.
Al elegir Suministros Vilchis, usted no solo adquiere insumos de laboratorio de alta calidad, sino que incorpora a su equipo un aliado comprometido con la precisión, la seguridad y la trazabilidad total.
Porque sabemos que en su laboratorio no hay margen para el error, y en nuestra logística, tampoco. En Suministros Vilchis, cada entrega lleva consigo un compromiso: la seguridad de que cada insumo proviene de una cadena controlada, documentada y confiable.
